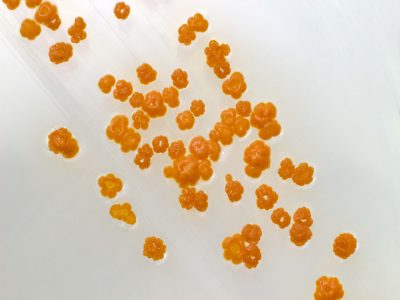
20-Caléndulas antibióticas

Caléndulas antibióticas
Publicada el 22/01/2026
Título: Caléndulas antibióticas
Autor: Fernando Román Hurtado
Fundación MEDINA, Avenida del Conocimiento, 3, 18016, Granada
Descripción: Cepa del género Actinoplanes recolectada en la República de Georgia. Este género ha sido ampliamente utilizado para el descubrimiento de moléculas bioactivas que conducen al desarrollo de nuevos antibióticos. Especies de este género producen compuestos farmacéuticamente importantes como valienamina, teicoplanina y ramoplanina. Foto tomada e mediante una cámara CANON EOS550D y un objetivo EF100mm f/8.8 Macro USM.